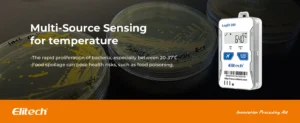

Elitech 4G Reusable Real-time Temperature Data Logger with Built-in SIM Card

For illumination

For Vibration

For Temperature
For humidity

For Location(LBS)

Shadow Data

Flight Mode

Waterproof IP65

LogEt 260 VS RCW-360Pro VS RCW-360Plus

Spesifikasi Teknis Elitech LogEt 260-TH
Perekaman & Upload Data
- Record Interval: 1 menit ~ 24 jam (default 5 menit)
- Upload Interval: 1 menit ~ 24 jam (default 60 menit)
- Offline Record: Hingga 100.000 titik data
- Logging Mode: Stop saat penuh / Circular logging (menimpa data lama)
Lingkungan Operasional & Penyimpanan
- Lingkungan Operasional: -30℃ ~ 70℃, 0% ~ 90% RH (non-condensing)
- Lingkungan Penyimpanan: 15℃ ~ 30℃, 20% ~ 75% RH
Baterai & Daya
- Jenis Baterai: Rechargeable lithium battery 3.7V 3000mAh
- Pengisian Daya: Port Type-C
Komunikasi & Lokasi
- Metode Komunikasi: 4G (dengan SIM card bawaan)
- Metode Lokasi: LBS (Location-Based Service)
Software & Laporan
- Kompatibilitas Software: macOS & Windows
- Format Laporan: PDF otomatis; PDF/Excel/TXT via software
- OTA Upgrade: Mendukung upgrade via software / platform (batch upgrade)
Proteksi & Sertifikasi
- Kelas Proteksi: IP65 (tahan debu & percikan air)




















